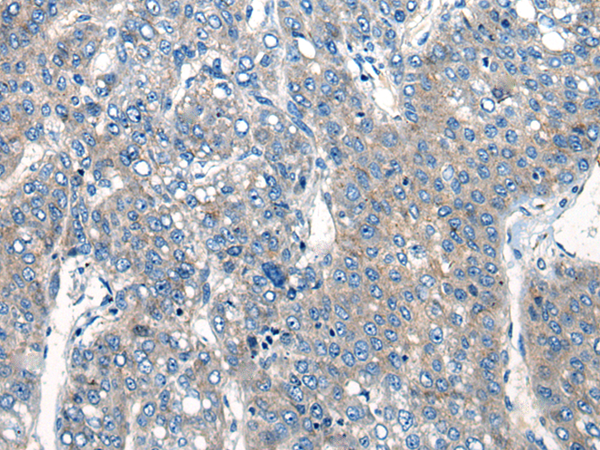

中文名稱:兔抗CLPX多克隆抗體
|
Background: |
The protein encoded by this gene is part of a protease found in mitochondria. This protease is ATP-dependent and targets specific proteins for degradation. The protease consists of two heptameric rings of the CLPP catalytic subunit sandwiched between two hexameric rings of the chaperone subunit encoded by this gene. Targeted proteins are unwound by this protein and then passed on to the CLPP subunit for degradation. Two transcript variants, one protein-coding and the other non-protein coding, have been found for this gene. |
|
Applications: |
ELISA, WB, IHC |
|
Name of antibody: |
CLPX |
|
Immunogen: |
Synthetic peptide of human CLPX |
|
Full name: |
caseinolytic mitochondrial matrix peptidase chaperone subunit |
|
SwissProt: |
O76031 |
|
ELISA Recommended dilution: |
5000-10000 |
|
IHC positive control: |
Human liver cancer and human thyroid cancer |
|
IHC Recommend dilution: |
20-100 |
|
WB Predicted band size: |
69 kDa |
|
WB Positive control: |
293T cell lysate |
|
WB Recommended dilution: |
200-1000 |

購物車
購物車 幫助
幫助
 021-54845833/15800441009
021-54845833/15800441009
